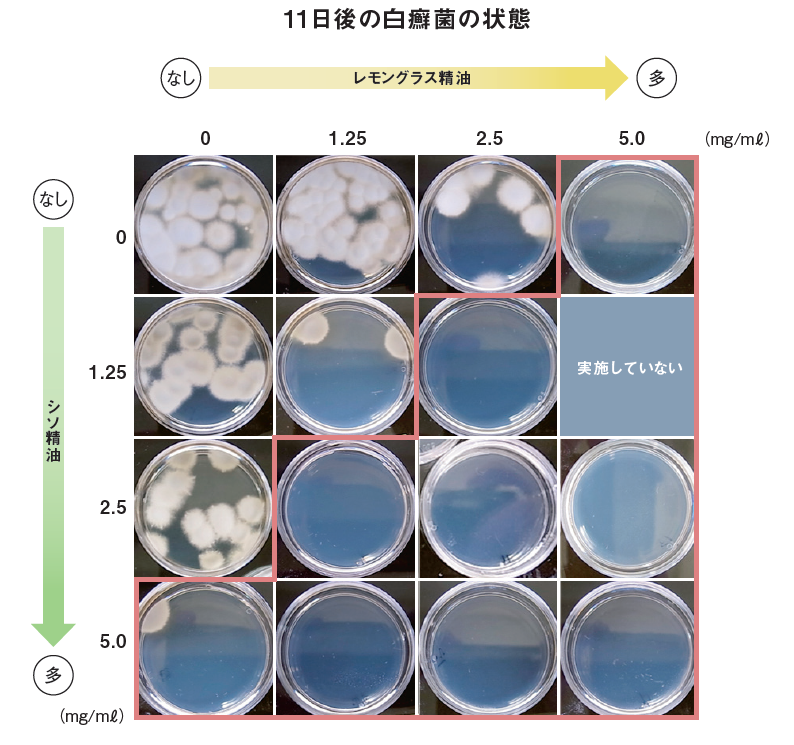

アロマテラピー検定・資格の認定、学術調査研究の実施
抗菌|Antibacterial
夏には日本人の4人に1人が罹患すると推定されている水虫。今回は、その原因となる白癬菌に対して精油の抗菌作用を検証した実験をご紹介します。
白癬菌を植え付けた培地のシャーレを、蓋を取って密閉箱の底に設置。
箱の天井にはレモングラス精油とシソ精油の希釈液 を染み込ませた紙を添付し、27℃で4日間培養した。
その後一度シャーレを取り出し、蓋をして同じ温度でさらに7日培養した。
※レモングラス精油とシソ精油の混合溶液をエタノールで希釈。
各濃度は実験結果の写真を参照。

レモングラス精油単独、シソ精油単独の場合には、濃度の増加により抗菌作用が高まることが示唆されました。
また、レモングラス精油とシソ精油の混合溶液では、赤線で囲まれた濃度において、白癬菌はほとんど認められなかったことから、より高い抗菌作用が確認されました。
つまり、2種の精油を混合したことで、相乗効果が得られる可能性が示唆されました。
論文 石島早苗,他 (2020) レモングラス精油とシソ精油の揮発性抗菌力を用いた白癬菌の除菌. Medical Mycology Research 11(1):47-54.